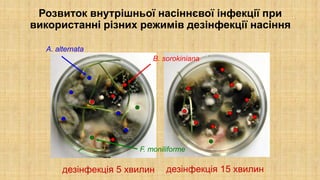
Розвиток внутрішньої насіннєвої інфекції при
використанні різних режимів дезінфекції насіння
дезінфекція 5 хвилин
B. sorokiniana
F. moniliforme
A. alternata
дезінфекція 15 хвилин

Embed presentation
Download as PDF, PPTX























Презентація до курсу "Загальна та сільськогосподарська фітопатологія", що його викладають на кафедрі мікології та фітоімунології біологічного факультету Харківського національного університету імені В.Н. Каразіна, Україна